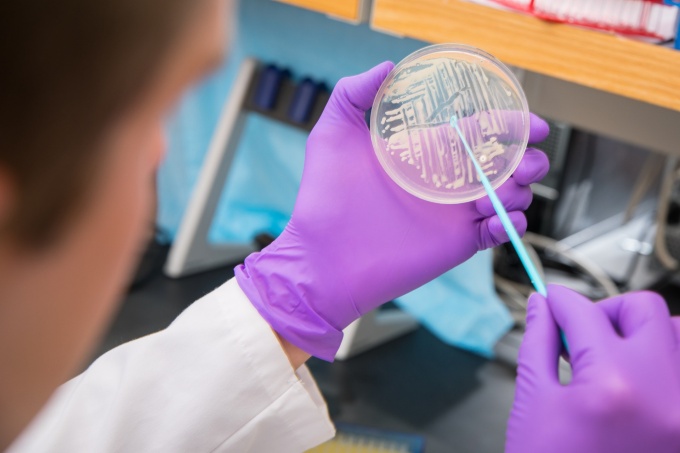
Researcher swabbing petri dish in lab.

EDUCATING LEADERS IN PHARMACY AND PHARMACEUTICAL SCIENCES SINCE 1886
Research
The Department of Pharmacy Practice conducts robust research spanning from drug interaction to clinical application.
The Department of Pharmacy Practice conducts robust research spanning from drug interaction to clinical application.